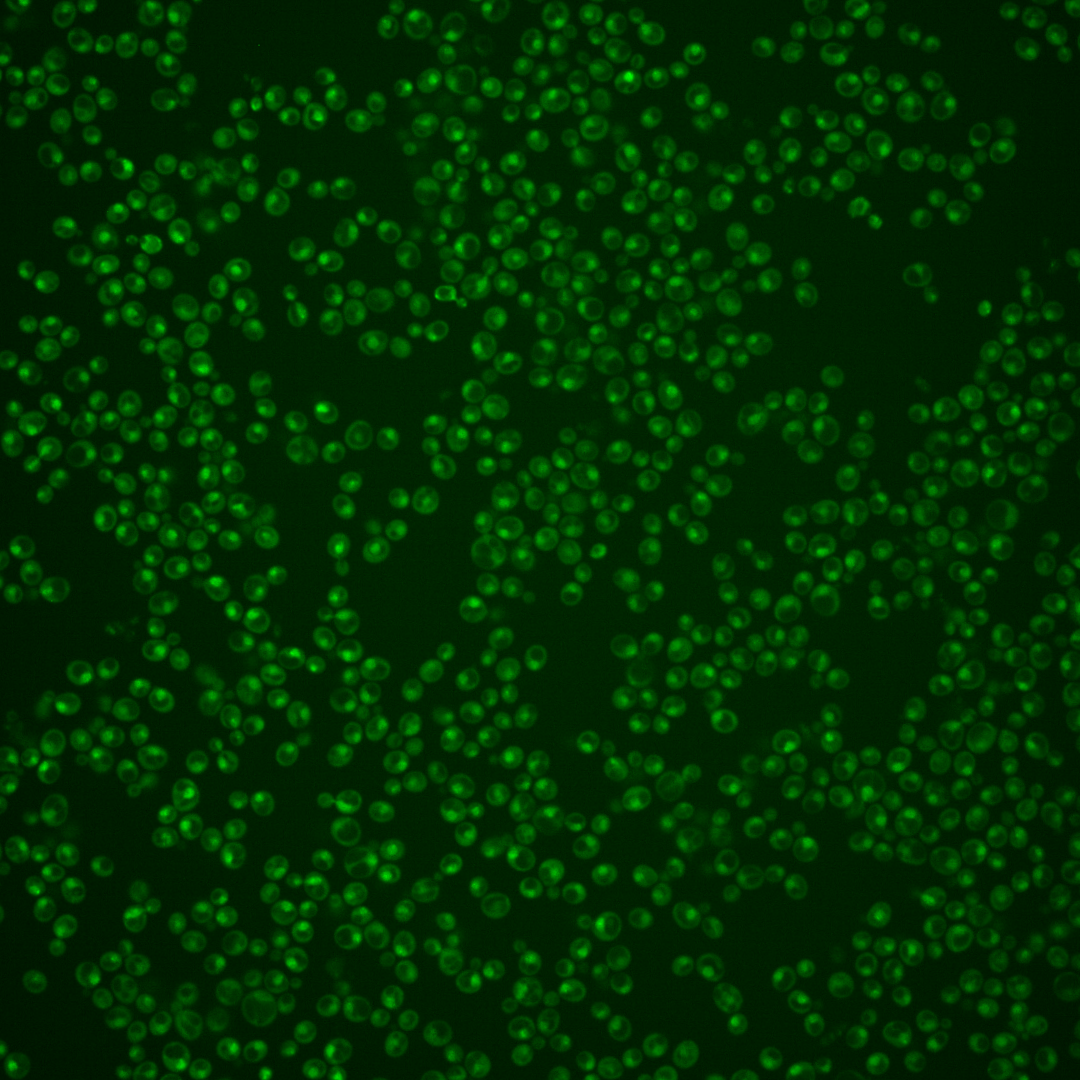
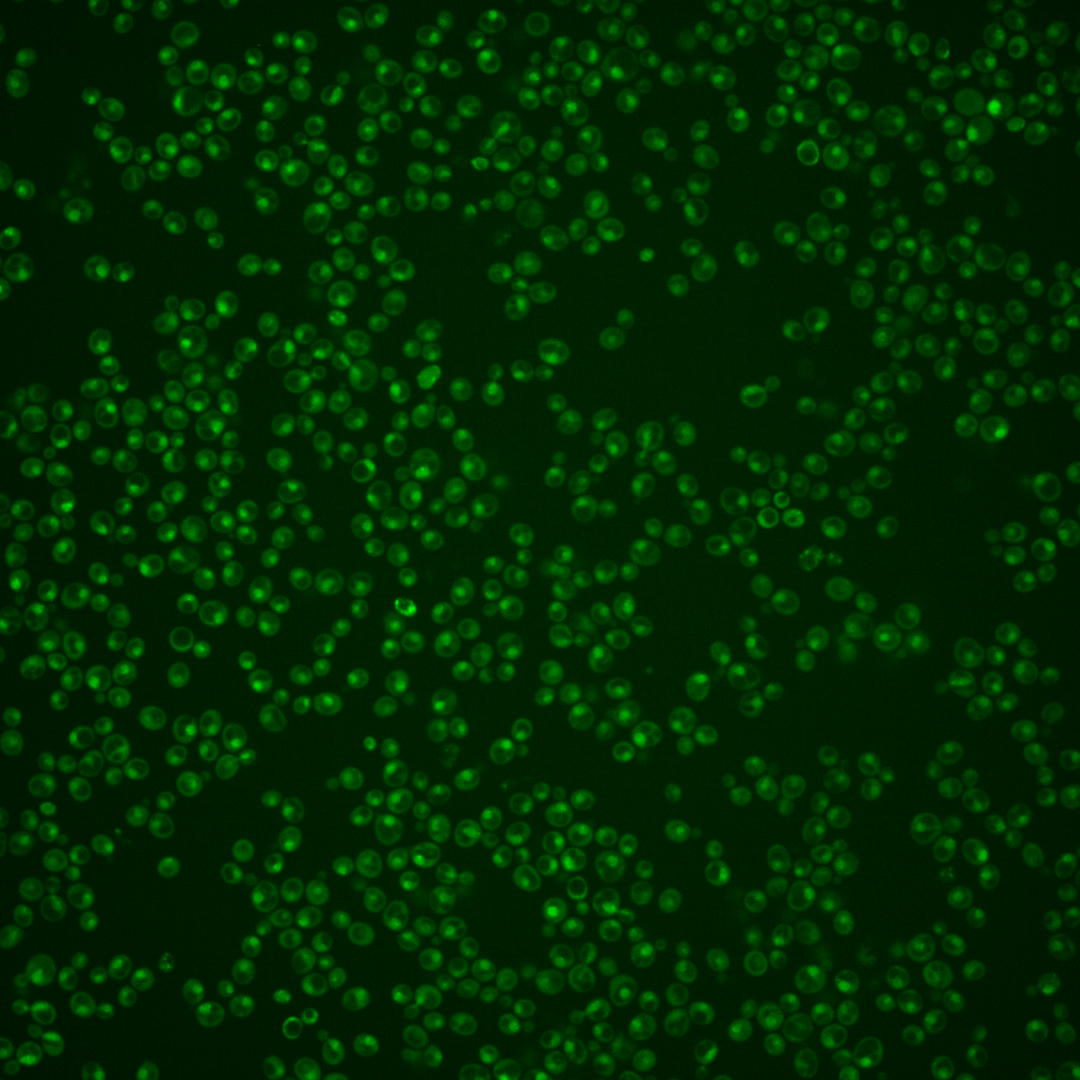

| Standard name | |
|---|---|
| Human Ortholog | |
| Description | Transcription factor that regulates the pleiotropic drug response; zinc cluster protein that is a master regulator involved in recruiting other zinc cluster proteins to pleiotropic drug response elements (PDREs) to fine tune the regulation of multidrug resistance genes; relocalizes to the cytosol in response to hypoxia; PDR1 has a paralog, PDR3, that arose from the whole genome duplication |
Micrographs




















































































Sub-cellular Localization
Yeast GFP Assignment
Protein Abundance
Localization Change
External localization resources
| ensLOC | DeepLoc | |||||||||||||||||||||||
|---|---|---|---|---|---|---|---|---|---|---|---|---|---|---|---|---|---|---|---|---|---|---|---|---|
| Localization | WT1 | WT2 | WT3 | RAP60 | RAP140 | RAP220 | RAP300 | RAP380 | RAP460 | RAP540 | RAP620 | RAP700 | HU80 | HU120 | HU160 | rpd3Δ_1 | rpd3Δ_2 | rpd3Δ_3 | WT1 | WT2 | WT3 | AF100 | AF140 | AF180 |
| Cortical Patches | 0 | 0 | 0 | 0 | 0 | 0 | 0 | 0 | 0 | 1 | 1 | 0 | 0 | 0 | 0 | 0 | 0 | 1 | 0 | 0 | 0 | 0 | 0 | 0 |
| Bud | 0 | 0 | 2 | 1 | 2 | 4 | 1 | 6 | 4 | 8 | 3 | 4 | 0 | 1 | 0 | 1 | 0 | 2 | 0 | 1 | 1 | 0 | 2 | 3 |
| Bud Neck | 0 | 0 | 0 | 0 | 0 | 0 | 0 | 2 | 0 | 0 | 0 | 0 | 0 | 0 | 0 | 0 | 0 | 0 | 0 | 0 | 0 | 0 | 1 | 1 |
| Bud Site | 0 | 0 | 4 | 0 | 6 | 22 | 19 | 43 | 13 | 15 | 8 | 26 | 0 | 1 | 1 | 0 | 0 | 1 | – | – | – | – | – | – |
| Cell Periphery | 0 | 0 | 0 | 0 | 0 | 0 | 0 | 0 | 1 | 0 | 0 | 1 | 0 | 1 | 0 | 0 | 0 | 0 | 0 | 0 | 0 | 0 | 0 | 0 |
| Cytoplasm | 3 | 1 | 5 | 4 | 6 | 8 | 9 | 8 | 9 | 8 | 7 | 6 | 17 | 32 | 45 | 52 | 25 | 40 | 0 | 0 | 1 | 0 | 1 | 1 |
| Endoplasmic Reticulum | 0 | 0 | 0 | 0 | 0 | 0 | 0 | 0 | 0 | 0 | 0 | 0 | 0 | 2 | 0 | 11 | 4 | 13 | 0 | 0 | 0 | 0 | 0 | 1 |
| Endosome | 1 | 0 | 0 | 0 | 1 | 0 | 0 | 0 | 0 | 0 | 0 | 0 | 0 | 0 | 1 | 11 | 4 | 6 | 1 | 0 | 1 | 2 | 3 | 10 |
| Golgi | 0 | 0 | 0 | 0 | 0 | 0 | 0 | 0 | 0 | 0 | 0 | 0 | 0 | 1 | 0 | 1 | 1 | 1 | 0 | 0 | 0 | 1 | 3 | 1 |
| Mitochondria | 4 | 63 | 139 | 152 | 116 | 233 | 298 | 405 | 292 | 327 | 262 | 347 | 9 | 8 | 49 | 30 | 11 | 55 | 4 | 0 | 2 | 1 | 3 | 7 |
| Nucleus | 159 | 116 | 213 | 212 | 328 | 331 | 442 | 531 | 246 | 292 | 240 | 301 | 142 | 214 | 230 | 608 | 369 | 511 | 157 | 117 | 186 | 72 | 189 | 146 |
| Nuclear Periphery | 1 | 0 | 0 | 0 | 2 | 12 | 24 | 13 | 6 | 14 | 14 | 11 | 0 | 3 | 0 | 2 | 0 | 4 | 1 | 0 | 0 | 0 | 0 | 2 |
| Nucleolus | 9 | 8 | 8 | 11 | 32 | 49 | 73 | 136 | 62 | 82 | 68 | 90 | 7 | 12 | 12 | 18 | 18 | 19 | 17 | 5 | 16 | 5 | 24 | 41 |
| Peroxisomes | 0 | 0 | 0 | 0 | 0 | 0 | 0 | 1 | 0 | 0 | 0 | 0 | 0 | 3 | 2 | 0 | 0 | 1 | 0 | 0 | 0 | 0 | 0 | 0 |
| SpindlePole | 0 | 0 | 3 | 2 | 4 | 4 | 7 | 16 | 0 | 4 | 3 | 3 | 0 | 2 | 2 | 9 | 5 | 6 | 1 | 0 | 4 | 1 | 3 | 11 |
| Vac/Vac Membrane | 1 | 4 | 2 | 2 | 2 | 1 | 1 | 0 | 3 | 0 | 0 | 5 | 1 | 3 | 3 | 26 | 9 | 19 | 6 | 6 | 23 | 4 | 28 | 45 |
| Unique Cell Count | 170 | 133 | 243 | 240 | 380 | 426 | 586 | 717 | 397 | 450 | 365 | 465 | 168 | 263 | 295 | 717 | 418 | 591 | 193 | 132 | 242 | 96 | 264 | 281 |
| Labelled Cell Count | 178 | 192 | 376 | 384 | 499 | 664 | 874 | 1161 | 636 | 751 | 606 | 794 | 176 | 283 | 345 | 769 | 446 | 679 | 193 | 132 | 242 | 96 | 264 | 281 |
Yeast GFP Assignment
Protein Abundance
| Screen | WT1 | WT2 | WT3 | RAP60 | RAP140 | RAP220 | RAP300 | RAP380 | RAP460 | RAP540 | RAP620 | RAP700 | HU80 | HU120 | HU160 | rpd3Δ_1 | rpd3Δ_2 | rpd3Δ_3 | AF100 | AF140 | AF180 |
|---|---|---|---|---|---|---|---|---|---|---|---|---|---|---|---|---|---|---|---|---|---|
| Mean Cell GFP Intensity (1e-4) | 6.7 | 4.3 | 3.8 | 3.8 | 4.3 | 3.8 | 3.8 | 3.8 | 3.3 | 3.4 | 3.3 | 3.2 | 5.8 | 6.0 | 5.2 | 7.3 | 7.7 | 8.2 | 5.2 | 5.6 | 6.0 |
| Std Deviation (1e-4) | 1.4 | 1.4 | 0.5 | 0.8 | 0.8 | 0.8 | 0.7 | 0.9 | 0.8 | 0.8 | 1.0 | 1.1 | 1.4 | 1.6 | 1.4 | 1.4 | 1.6 | 1.6 | 0.9 | 1.2 | 1.1 |
| Intensity Change (Log2) | – | – | – | -0.0 | 0.17 | 0.01 | -0.01 | 0.02 | -0.19 | -0.15 | -0.17 | -0.25 | 0.63 | 0.68 | 0.45 | 0.95 | 1.04 | 1.11 | 0.46 | 0.56 | 0.67 |
Localization Change
| Localization | RAP60 | RAP140 | RAP220 | RAP300 | RAP380 | RAP460 | RAP540 | RAP620 | RAP700 | HU80 | HU120 | HU160 | rpd3Δ_1 | rpd3Δ_2 | rpd3Δ_3 |
|---|---|---|---|---|---|---|---|---|---|---|---|---|---|---|---|
| Actin | – | – | – | – | – | – | – | – | – | – | – | – | – | – | – |
| Bud | – | – | – | – | – | – | – | – | – | – | – | – | 0 | – | 0 |
| Bud Neck | – | – | – | – | – | – | – | – | – | – | – | – | 0 | – | 0 |
| Bud Site | – | – | – | – | – | – | – | – | – | – | – | – | 0 | – | 0 |
| Cell Periphery | – | – | – | – | – | – | – | – | – | – | – | – | 0 | – | 0 |
| Cyto | – | – | – | – | – | – | – | – | – | – | – | – | – | – | – |
| Endoplasmic Reticulum | – | – | – | – | – | – | – | – | – | – | – | – | 0 | – | 0 |
| Endosome | – | – | – | – | – | – | – | – | – | – | – | – | 0 | – | 0 |
| Golgi | – | – | – | – | – | – | – | – | – | – | – | – | 0 | – | 0 |
| Mitochondria | – | – | – | – | – | – | – | – | – | – | – | – | 0 | – | 0 |
| Nuclear Periphery | – | – | – | – | – | – | – | – | – | – | – | – | 0 | – | 0 |
| Nuc | – | – | – | – | – | – | – | – | – | – | – | – | – | – | – |
| Nucleolus | – | – | – | – | – | – | – | – | – | – | – | – | 0 | – | 0 |
| Peroxisomes | – | – | – | – | – | – | – | – | – | – | – | – | 0 | – | 0 |
| SpindlePole | – | – | – | – | – | – | – | – | – | – | – | – | 0 | – | 0 |
| Vac | – | – | – | – | – | – | – | – | – | – | – | – | – | – | – |
| Cortical Patches | – | – | – | – | – | – | – | – | – | – | – | – | 0 | – | 0 |
| Cytoplasm | – | – | – | – | – | – | – | – | – | – | – | – | 0 | – | 0 |
| Nucleus | – | – | – | – | – | – | – | – | – | – | – | – | 0 | – | 0 |
| Vacuole | – | – | – | – | – | – | – | – | – | – | – | – | 2.2 | – | 2.0 |
External localization resources
Images






























Protein Concentration and Protein Localization Data
| R1 | R2 | R3 | ||||||||||||||||
|---|---|---|---|---|---|---|---|---|---|---|---|---|---|---|---|---|---|---|
| G1 Pre-START | G1 Post-START | S/G2 | Metaphase | Anaphase | Telophase | G1 Pre-START | G1 Post-START | S/G2 | Metaphase | Anaphase | Telophase | G1 Pre-START | G1 Post-START | S/G2 | Metaphase | Anaphase | Telophase | |
| Concentration | 3.2247 | 3.9352 | 3.273 | 2.6206 | 2.2912 | 3.2145 | 3.9176 | 4.3192 | 3.7495 | 3.2184 | 3.667 | 3.8613 | 3.9542 | 3.5419 | 3.7642 | 3.4499 | 3.9465 | 3.3692 |
| Actin | 0.0229 | 0 | 0.0007 | 0 | 0.0118 | 0.0032 | 0.0159 | 0 | 0.0112 | 0.0335 | 0.0058 | 0.0003 | 0.0184 | 0 | 0.0002 | 0 | 0.0001 | 0.0001 |
| Bud | 0.0006 | 0 | 0.0001 | 0 | 0.0001 | 0.0001 | 0.0014 | 0 | 0.0008 | 0.0024 | 0.0017 | 0.0001 | 0.0002 | 0 | 0 | 0 | 0.0001 | 0 |
| Bud Neck | 0.0024 | 0.0001 | 0.0001 | 0.0001 | 0.0033 | 0.0011 | 0.0015 | 0.0001 | 0.0007 | 0.0007 | 0.0013 | 0.0007 | 0.0002 | 0.0001 | 0.0002 | 0 | 0.0006 | 0.0003 |
| Bud Periphery | 0.0011 | 0 | 0.0004 | 0 | 0.0003 | 0.0001 | 0.004 | 0 | 0.0008 | 0.0032 | 0.0061 | 0.0003 | 0.0004 | 0 | 0.0001 | 0 | 0.0002 | 0.0001 |
| Bud Site | 0.0029 | 0 | 0.0002 | 0 | 0.0005 | 0.0002 | 0.0032 | 0 | 0.0034 | 0.0044 | 0.0031 | 0.0001 | 0.0002 | 0 | 0 | 0 | 0.0002 | 0.0001 |
| Cell Periphery | 0.0004 | 0 | 0.0001 | 0 | 0.0001 | 0.0001 | 0.001 | 0 | 0.0001 | 0.0002 | 0.0007 | 0.0001 | 0.0001 | 0 | 0 | 0 | 0 | 0.0001 |
| Cytoplasm | 0.0028 | 0.0001 | 0.0001 | 0 | 0.0003 | 0.0001 | 0.0117 | 0 | 0.0017 | 0.0069 | 0.0033 | 0.0001 | 0.0002 | 0 | 0.0003 | 0.0001 | 0.0002 | 0.0004 |
| Cytoplasmic Foci | 0.0102 | 0 | 0.0002 | 0 | 0.0031 | 0.0002 | 0.0375 | 0 | 0.0194 | 0.0162 | 0.0344 | 0.0003 | 0.0008 | 0 | 0.0002 | 0 | 0 | 0.0008 |
| Eisosomes | 0.0002 | 0 | 0 | 0 | 0.0001 | 0 | 0.0003 | 0 | 0.0001 | 0.0002 | 0.0001 | 0 | 0.0001 | 0 | 0 | 0 | 0 | 0 |
| Endoplasmic Reticulum | 0.0042 | 0 | 0.0003 | 0 | 0.0005 | 0.0002 | 0.0142 | 0 | 0.0008 | 0.0051 | 0.0032 | 0.0009 | 0.0009 | 0 | 0.0015 | 0 | 0 | 0.0003 |
| Endosome | 0.0221 | 0 | 0.0026 | 0 | 0.0077 | 0.0008 | 0.0449 | 0 | 0.0056 | 0.0131 | 0.0593 | 0.0044 | 0.0022 | 0 | 0.0005 | 0 | 0.0001 | 0.0019 |
| Golgi | 0.0077 | 0 | 0.0006 | 0 | 0.0045 | 0.0006 | 0.0099 | 0 | 0.0069 | 0.0072 | 0.0184 | 0.0011 | 0.0016 | 0 | 0 | 0 | 0 | 0.0003 |
| Lipid Particles | 0.0307 | 0 | 0.0009 | 0 | 0.01 | 0.0011 | 0.0231 | 0 | 0.0033 | 0.0178 | 0.0211 | 0.004 | 0.0039 | 0 | 0.0001 | 0 | 0 | 0.0068 |
| Mitochondria | 0.006 | 0.0002 | 0.0051 | 0.0001 | 0.0015 | 0.0003 | 0.0222 | 0.0002 | 0.0121 | 0.0064 | 0.0367 | 0.0075 | 0.0012 | 0.0001 | 0.0005 | 0.0001 | 0.0007 | 0.0016 |
| None | 0.0048 | 0 | 0.0001 | 0 | 0.0008 | 0.0001 | 0.0061 | 0 | 0.0003 | 0.033 | 0.0009 | 0 | 0.0003 | 0 | 0.0127 | 0 | 0.0003 | 0.0004 |
| Nuclear Periphery | 0.0194 | 0.0063 | 0.0047 | 0.0012 | 0.0309 | 0.0016 | 0.0254 | 0.0006 | 0.0035 | 0.0062 | 0.0053 | 0.0012 | 0.0018 | 0.0005 | 0.0129 | 0.0011 | 0.0048 | 0.0004 |
| Nucleolus | 0.0616 | 0.0197 | 0.0399 | 0.0328 | 0.1812 | 0.0705 | 0.0403 | 0.0247 | 0.0125 | 0.0109 | 0.0727 | 0.0519 | 0.026 | 0.0282 | 0.0153 | 0.0156 | 0.1183 | 0.0407 |
| Nucleus | 0.7635 | 0.9727 | 0.9404 | 0.9649 | 0.7321 | 0.918 | 0.6877 | 0.9739 | 0.8975 | 0.7955 | 0.692 | 0.925 | 0.9392 | 0.9703 | 0.9483 | 0.9821 | 0.8672 | 0.9431 |
| Peroxisomes | 0.004 | 0 | 0.0002 | 0 | 0.0034 | 0.0003 | 0.009 | 0 | 0.0112 | 0.0053 | 0.0057 | 0.0001 | 0.0003 | 0 | 0 | 0 | 0 | 0.0003 |
| Punctate Nuclear | 0.0265 | 0.0004 | 0.0015 | 0.0007 | 0.0069 | 0.0012 | 0.0277 | 0.0002 | 0.0066 | 0.029 | 0.0029 | 0.0003 | 0.0011 | 0.0005 | 0.0057 | 0.0009 | 0.0066 | 0.0014 |
| Vacuole | 0.0041 | 0.0002 | 0.001 | 0 | 0.0005 | 0.0002 | 0.0083 | 0.0001 | 0.001 | 0.0019 | 0.0131 | 0.0009 | 0.0004 | 0.0002 | 0.0008 | 0 | 0.0002 | 0.0007 |
| Vacuole Periphery | 0.0016 | 0.0003 | 0.0008 | 0 | 0.0005 | 0.0001 | 0.0046 | 0.0001 | 0.0004 | 0.0007 | 0.0124 | 0.0005 | 0.0004 | 0.0001 | 0.0005 | 0 | 0.0002 | 0.0002 |
Sequencing Data
| R1 | R2 | |||||||||
|---|---|---|---|---|---|---|---|---|---|---|
| G1 Post-START | S/G2 | Metaphase | Anaphase | Telophase | G1 Post-START | S/G2 | Metaphase | Anaphase | Telophase | |
| Gene Expression | 22.192 | 28.9116 | 24.4206 | 28.1134 | 20.5202 | 25.7903 | 34.0527 | 36.1016 | 30.4583 | 31.6452 |
| Translational Efficiency | 0.5513 | 0.6424 | 0.5447 | 0.4158 | 0.526 | 0.5694 | 0.539 | 0.4068 | 0.4763 | 0.4074 |
Hit Data
| Dataset | Hit |
|---|---|
| Protein Concentration | ✔ |
| Protein Localization | ✘ |
| Gene Expression | ✔ |
| Translational Efficiency | ✘ |
Endocytosis
| Temp | Actin Patch (Sac6-tdTomato) | Cortical Patch (Sla1-GFP) | Late Endosome (Snf7-GFP) | Vacuole (Vph1-GFP) |
|---|---|---|---|---|
| 37℃ | ||||
| RT |
Cell Cycle Omics
CYCLoPs (Pdr1-GFP)
| Gene / Allele | Actin Patch (Sac6-tdTomato) | Cortical Patch (Sla1-GFP) | Late Endosome (Snf7-GFP) | Vacuole (Sac6-tdTomato) |
|---|
| Gene | Images |
|---|
| Gene | Images |
|---|
Images are not yet available
Images are not yet available